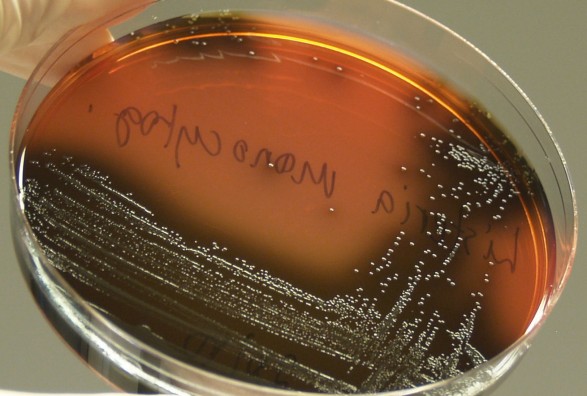

Shkurt.ch
Bakteret e modifikuara, shpresë në luftën kundër kancerit
Shkencëtarët tashmë kanë realizuar sukseset e para te pacientet me kancer në mitër.
Shkencëtarët nga universiteti Albert Einstein College of Medicine i Nju Jorkut duan që me bakteret e llojit Listeria monocytogenes të luftojnë tipe të ndryshme të kancerit.
Këto baktere janë parazite intracelulare dhe si të tilla, sipas rregullit, mund t`i shkaktojnë edhe vetë dëme të rënda indeve njerëzore. Por, pasi të modifikohen gjenetikisht, ato mund të mbijetojnë një kohë fare të shkurtë në trupin e njeriut dhe pastaj bëhen të padëmshme, shkruan siegelonline.de.
Detyrë e listerieve është transportimi i antigjeneve specifike për tumoret dhe mbështetka e sistemit të imunitetit. Shkencëtarët tashmë kanë realizuar sukseset e para te pacientet me kancer në mitër.
E-Diaspora
-
 Boksieri shqiptar Luis Vela shpallet kampion i WBC International në moshën 19-vjeçare Talenti me rrënjë shqiptare vazhdon ngjitjen në arenën ndërkombëtare të boksit, duke fituar titullin prestigjioz në...
Boksieri shqiptar Luis Vela shpallet kampion i WBC International në moshën 19-vjeçare Talenti me rrënjë shqiptare vazhdon ngjitjen në arenën ndërkombëtare të boksit, duke fituar titullin prestigjioz në... -
 Pianistja shqiptare Fatjona Maliqi interpretoi veprën monumentale të Bach-ut në Gjermani
Pianistja shqiptare Fatjona Maliqi interpretoi veprën monumentale të Bach-ut në Gjermani -
Gjermani
 Shqiptarja Lindita Nebiu Hyseni ligjëruese në Universitetin SRH në Mynih
Shqiptarja Lindita Nebiu Hyseni ligjëruese në Universitetin SRH në Mynih -
 Profesoresha nga Kosova ligjëron në Universitetin e Regensburgut në Gjermani
Profesoresha nga Kosova ligjëron në Universitetin e Regensburgut në Gjermani -
 Venera prezanton Kosovën në kongresin botëror të endokrinologjisë në SHBA
Venera prezanton Kosovën në kongresin botëror të endokrinologjisë në SHBA
Jeta në Austri
-
 Më pak se 50% i kalojnë provimet e integrimit A2/B1 të Austrisë Shkalla e kalueshmërisë së provimeve të integrimit A2 dhe B1 në Austri ka rënë nën 50%....
Më pak se 50% i kalojnë provimet e integrimit A2/B1 të Austrisë Shkalla e kalueshmërisë së provimeve të integrimit A2 dhe B1 në Austri ka rënë nën 50%.... -
 Mbylljet e Transportit Publik të Vjenës në vitin 2026: Ndërprerje të S-Bahn, U3, U4
Mbylljet e Transportit Publik të Vjenës në vitin 2026: Ndërprerje të S-Bahn, U3, U4 -
 Austria bie dakord për rregulla të reja për vetëvrasjen e asistuar
Austria bie dakord për rregulla të reja për vetëvrasjen e asistuar -
 Mbyllet procesi i votimit në Vjenë: Votuan 907 qytetarë
Mbyllet procesi i votimit në Vjenë: Votuan 907 qytetarë -
 Përfundon procesi i votimit në qendrat diplomatike të Kosovës në Evropë
Përfundon procesi i votimit në qendrat diplomatike të Kosovës në Evropë
























